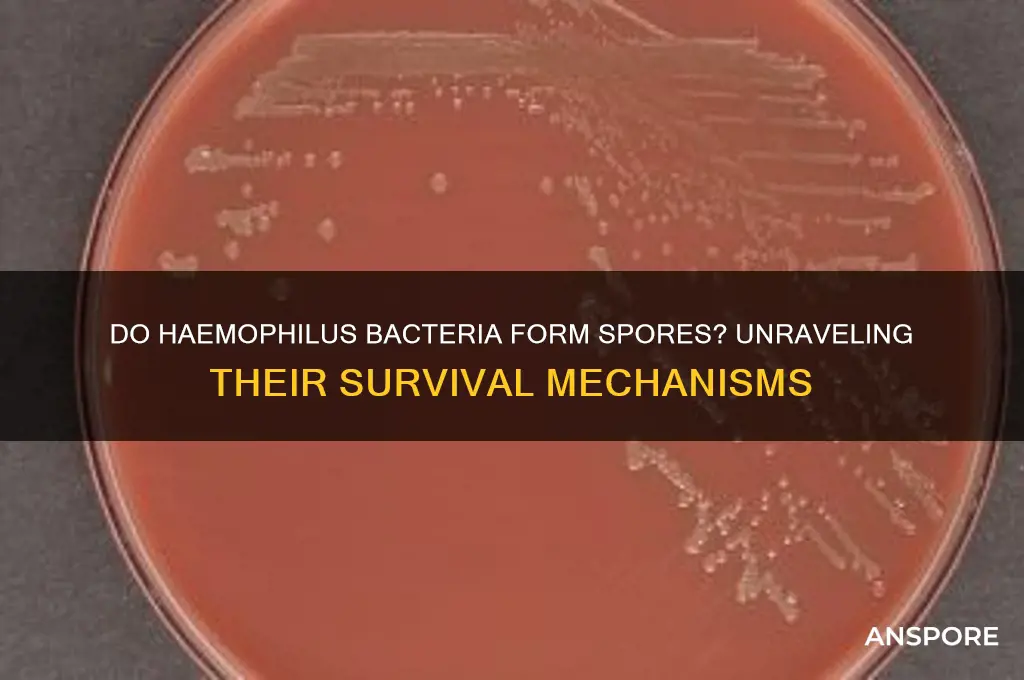
do haemophilus form spores

Haemophilus species are a group of Gram-negative bacteria primarily known for their role in respiratory and systemic infections, such as otitis media, pneumonia, and meningitis. Unlike some other bacterial genera, Haemophilus does not form spores, a characteristic that distinguishes it from spore-forming bacteria like Bacillus and Clostridium. Instead, Haemophilus relies on its ability to colonize mucosal surfaces and evade host immune responses for survival. Its non-spore-forming nature makes it more susceptible to environmental stresses and disinfection methods, but it also highlights its adaptation to specific ecological niches within the human body. Understanding this aspect of Haemophilus biology is crucial for developing effective prevention and treatment strategies against infections caused by these pathogens.
| Characteristics | Values |
|---|---|
| Spore Formation | No, Haemophilus species do not form spores. |
| Cell Shape | Coccobacilli (short, pleomorphic rods) |
| Gram Staining | Gram-negative |
| Oxygen Requirement | Facultative anaerobes (prefer aerobic conditions but can survive without oxygen) |
| Metabolism | Require preformed growth factors (e.g., NAD or hemin) for growth |
| Capsule | Some species (e.g., H. influenzae) produce a polysaccharide capsule |
| Motility | Non-motile |
| Habitat | Primarily found in the human respiratory tract as part of the normal flora |
| Pathogenicity | Can cause infections such as meningitis, pneumonia, and otitis media |
| Antibiotic Susceptibility | Susceptible to beta-lactams, but resistance (e.g., beta-lactamase production) is increasingly common |
| Sporulation Genes | Absent; lack genetic machinery for spore formation |
| Survival Outside Host | Limited; does not survive well in the environment without a host |
Explore related products
What You'll Learn
- Sporulation Process: Haemophilus species lack the ability to form spores under any conditions
- Cell Structure: Absence of sporulation genes and mechanisms in Haemophilus genomes
- Environmental Survival: Haemophilus relies on biofilms, not spores, for survival outside hosts
- Comparison with Sporulators: Unlike Bacillus or Clostridium, Haemophilus does not produce endospores
- Clinical Relevance: Non-sporulating nature impacts Haemophilus treatment and infection control strategies

Sporulation Process: Haemophilus species lack the ability to form spores under any conditions
Haemophilus species are Gram-negative bacteria known for their fastidious growth requirements and dependence on specific nutrients like hemin (X factor) and nicotinamide adenine dinucleotide (V factor). Despite their adaptability to diverse environments, one critical limitation stands out: they lack the genetic and physiological mechanisms required for sporulation. Unlike spore-forming bacteria such as Bacillus or Clostridium, Haemophilus species do not produce endospores under any conditions, including nutrient deprivation, extreme temperatures, or other stressors. This absence of sporulation is rooted in their genomic makeup, which lacks the sporulation-related genes essential for initiating and completing the complex sporulation process.
From an analytical perspective, the inability of Haemophilus species to form spores significantly impacts their survival strategies. Spores serve as a dormant, highly resistant form that allows bacteria to endure harsh conditions for extended periods. Without this capability, Haemophilus relies on other mechanisms, such as biofilm formation and rapid metabolic adaptation, to persist in hostile environments. For instance, Haemophilus influenzae, a common human pathogen, often colonizes the respiratory tract by forming biofilms that protect it from host immune responses and antibiotics. However, this reliance on biofilms also makes it more vulnerable to environmental changes compared to spore-forming bacteria, which can remain viable for decades in a dormant state.
Instructively, understanding the non-sporulating nature of Haemophilus is crucial for laboratory handling and clinical management. Since these bacteria do not form spores, standard sterilization methods like autoclaving (121°C for 15 minutes) are effective in eliminating them. However, in clinical settings, their lack of sporulation means they cannot survive long outside a host, reducing their environmental persistence. For researchers, this characteristic simplifies culturing processes, as there is no need to account for spore activation or germination. Instead, focus should be placed on providing the necessary growth factors (X and V factors) and maintaining optimal conditions (35–37°C, 5% CO2) for successful cultivation.
Persuasively, the absence of sporulation in Haemophilus species highlights their evolutionary trade-offs. While spore formation offers long-term survival advantages, it also requires significant energy investment and complex regulatory pathways. Haemophilus, being an obligate parasite or commensal of humans and animals, has evolved to thrive in nutrient-rich environments where sporulation is unnecessary. This specialization allows them to allocate resources toward rapid replication and host adaptation rather than energy-intensive survival structures. However, this also limits their ability to survive outside a host, making them less likely to cause environmental contamination or outbreaks compared to spore-forming pathogens like Clostridium difficile.
Comparatively, the sporulation process in bacteria like Bacillus subtilis involves a series of tightly regulated steps, including asymmetric cell division, spore coat formation, and cortex synthesis. In contrast, Haemophilus species lack the sporulation operons (e.g., spo0A, sigE) that drive these processes. This genetic deficiency underscores their evolutionary divergence from spore-formers, which have retained these pathways as a survival strategy. For example, while Bacillus spores can withstand boiling temperatures and desiccation, Haemophilus cells are rapidly inactivated by similar conditions, further emphasizing their reliance on host environments for survival. This comparison not only highlights the uniqueness of Haemophilus but also underscores the diversity of bacterial survival strategies in nature.
Can Mold Spores Penetrate Plastic Bags? Uncovering the Truth
You may want to see also

Cell Structure: Absence of sporulation genes and mechanisms in Haemophilus genomes
Haemophilus species are known for their fastidious nature and specific growth requirements, yet they lack a critical survival mechanism found in many other bacteria: the ability to form spores. This absence is rooted in their genomic structure, which notably excludes the genes and mechanisms necessary for sporulation. Unlike spore-forming bacteria such as Bacillus or Clostridium, Haemophilus genomes do not encode the complex machinery required to initiate, regulate, or complete the sporulation process. This genetic deficiency is a defining feature of their cell structure and has significant implications for their survival strategies and ecological niches.
Analyzing the genomes of Haemophilus species reveals a striking absence of key sporulation genes, such as those involved in the formation of the spore coat, cortex, and germination mechanisms. For instance, genes like *spo0A*, which acts as a master regulator of sporulation in Bacillus subtilis, are entirely absent in Haemophilus. Similarly, genes responsible for the synthesis of dipicolinic acid, a critical component of bacterial spores, are missing. This genetic void underscores the evolutionary divergence of Haemophilus from spore-forming bacteria, as they have instead adapted to rely on other mechanisms for survival, such as their ability to colonize specific host environments like the human respiratory tract.
From a practical standpoint, the absence of sporulation genes in Haemophilus genomes simplifies their cultivation and control in laboratory settings. Unlike spore-formers, which can survive harsh conditions and require extreme measures for eradication, Haemophilus species are more susceptible to environmental stressors. For example, standard sterilization techniques, such as autoclaving at 121°C for 15 minutes, are effective against Haemophilus because they lack the resilient spore structure. Researchers and clinicians can leverage this knowledge to design targeted antimicrobial strategies, ensuring that disinfection protocols are both efficient and appropriate for Haemophilus-contaminated environments.
Comparatively, the absence of sporulation mechanisms in Haemophilus highlights their evolutionary trade-offs. While spore-formers gain a survival advantage in diverse and hostile environments, Haemophilus has specialized in exploiting nutrient-rich, protected niches within hosts. This specialization is reflected in their genomic economy, where resources are allocated to genes supporting adhesion, nutrient acquisition, and immune evasion rather than sporulation. For instance, Haemophilus influenzae possesses genes encoding adhesins and capsule synthesis, which are critical for its pathogenicity but unrelated to spore formation. This comparative analysis underscores the principle that bacterial genomes are finely tuned to their ecological roles, with sporulation being a luxury Haemophilus has forgone.
In conclusion, the absence of sporulation genes and mechanisms in Haemophilus genomes is a defining feature of their cell structure and survival strategy. This genetic void not only distinguishes them from spore-forming bacteria but also shapes their interactions with hosts and environments. Understanding this aspect of their biology provides valuable insights for both research and clinical applications, from laboratory cultivation to infection control. By focusing on what Haemophilus lacks, we gain a deeper appreciation for the diversity of bacterial survival strategies and the evolutionary forces that shape them.
Are Fern Spores Haploid? Unraveling the Mystery of Fern Reproduction
You may want to see also

Environmental Survival: Haemophilus relies on biofilms, not spores, for survival outside hosts
Unlike spore-forming bacteria that endure harsh conditions through dormancy, *Haemophilus* species lack the ability to produce spores. Instead, their survival outside a host depends on biofilm formation—a communal, protective matrix of extracellular polymeric substances (EPS). This biofilm shields *Haemophilus* from environmental stressors like desiccation, antibiotics, and host immune responses, enabling persistence on surfaces or in respiratory droplets. For instance, *H. influenzae* can survive for hours on fomites, increasing transmission risk in healthcare settings. Understanding this mechanism is crucial for infection control, as biofilm disruption (e.g., via enzymatic agents or antimicrobial surfaces) may reduce environmental reservoirs more effectively than targeting spores.
To combat *Haemophilus* biofilms, consider these practical steps: First, implement regular disinfection protocols using biofilm-penetrating agents like chlorine-based cleaners (0.5% sodium hypochlorite) or acetic acid (2–4% concentration). Second, maintain humidity below 50% in clinical environments, as biofilms thrive in moist conditions. Third, educate staff on hand hygiene, particularly after contact with potentially contaminated surfaces, using alcohol-based rubs (60–95% ethanol or isopropanol) for at least 20 seconds. For high-risk areas, such as pediatric wards, incorporate copper alloys into frequently touched surfaces, as copper ions disrupt biofilm integrity. These measures collectively target *Haemophilus*’s reliance on biofilms, mitigating its environmental survival.
Comparatively, while spore-forming pathogens like *Clostridioides difficile* require extreme measures (e.g., sporicidal agents like hydrogen peroxide vapor), *Haemophilus* biofilms are more susceptible to mechanical disruption and common disinfectants. However, their ability to rapidly form biofilms in nutrient-rich environments (e.g., respiratory secretions) poses a unique challenge. For example, *H. influenzae* biofilms in middle ear fluid contribute to chronic otitis media, necessitating biofilm-aware antibiotic regimens (e.g., high-dose amoxicillin-clavulanate, 90 mg/kg/day for children) to penetrate EPS and eradicate embedded bacteria. This highlights the need to differentiate between spore- and biofilm-based survival strategies in clinical management.
Descriptively, a *Haemophilus* biofilm resembles a microscopic fortress, with bacteria embedded in a gelatinous EPS scaffold composed of polysaccharides, proteins, and DNA. This structure facilitates quorum sensing, nutrient sharing, and genetic exchange, enhancing virulence and antibiotic resistance. In contrast to spores, which are dormant and metabolically inert, biofilm cells remain active, allowing rapid adaptation to environmental changes. For instance, *H. parasuis* biofilms in swine farms persist on feeding troughs, causing systemic infections in pigs despite routine cleaning. Visualizing this dynamic architecture through confocal microscopy underscores the importance of targeting EPS components (e.g., with DNase or dispersin B) to dismantle *Haemophilus*’s survival mechanism.
Persuasively, the focus on biofilms over spores in *Haemophilus* management shifts the paradigm from eradication to disruption. Unlike spores, which require complete elimination, biofilms can be controlled by inhibiting adhesion (e.g., using anti-adhesive coatings on medical devices) or dispersing established colonies. This approach aligns with the growing emphasis on microbiome preservation, as biofilm disruption minimizes collateral damage to beneficial flora. For parents of children at risk for *H. influenzae* infections, simple interventions like replacing toothbrushes monthly and avoiding shared utensils reduce biofilm exposure. By prioritizing biofilm-centric strategies, we address *Haemophilus*’s environmental resilience more effectively than if spores were the concern.
Can Mold Spores Survive on Metal Surfaces? Facts and Insights
You may want to see also
Explore related products

Comparison with Sporulators: Unlike Bacillus or Clostridium, Haemophilus does not produce endospores
Haemophilus species stand in stark contrast to spore-forming bacteria like Bacillus and Clostridium, which are renowned for their ability to produce highly resistant endospores. These endospores allow Bacillus and Clostridium to survive extreme conditions, including heat, desiccation, and radiation, making them formidable pathogens and environmental survivors. Haemophilus, however, lacks this survival mechanism, rendering it more susceptible to environmental stresses and antimicrobial agents. This fundamental difference in physiology has significant implications for their clinical management and laboratory handling.
From a clinical perspective, the inability of Haemophilus to form spores simplifies infection control measures. Unlike spore-formers, which require specialized sterilization techniques such as autoclaving at 121°C for 15–30 minutes, Haemophilus can be effectively eliminated with standard disinfection protocols. For instance, ethanol-based hand sanitizers (at least 60% ethanol) and common disinfectants like 70% isopropyl alcohol are sufficient to inactivate Haemophilus. This is particularly important in healthcare settings, where preventing the spread of Haemophilus influenzae, a common cause of respiratory infections in children under 5 years, is critical.
Laboratory handling of Haemophilus also differs markedly from that of sporulators. While Bacillus and Clostridium can survive for years in spore form, Haemophilus requires strict nutrient and environmental conditions to remain viable. For example, Haemophilus is fastidious, growing best on chocolate agar or media supplemented with factors V (NAD) and X (hemin). This dependency on specific growth conditions makes Haemophilus less likely to persist in non-clinical environments, reducing its potential for contamination in laboratory settings.
The absence of spore formation in Haemophilus also influences its role in disease pathogenesis. Unlike Clostridium botulinum, which can survive in canned foods as spores and cause botulism upon germination, Haemophilus infections are typically acquired through respiratory droplets or direct contact. This limits its transmission routes and underscores the importance of targeted preventive measures, such as vaccination against Haemophilus influenzae type b (Hib) for infants starting at 2 months of age, with a recommended series of 3–4 doses depending on the vaccine formulation.
In summary, the inability of Haemophilus to form spores distinguishes it from sporulators like Bacillus and Clostridium, shaping its clinical, laboratory, and epidemiological characteristics. This distinction not only simplifies infection control but also highlights the importance of tailored strategies for managing Haemophilus-related diseases. Understanding these differences is essential for healthcare professionals, microbiologists, and public health practitioners alike.
Can Iodine Effectively Kill Spores? Exploring Its Antimicrobial Power
You may want to see also

Clinical Relevance: Non-sporulating nature impacts Haemophilus treatment and infection control strategies
Haemophilus species, unlike spore-forming bacteria such as Clostridium or Bacillus, lack the ability to produce spores. This non-sporulating nature significantly influences clinical management, particularly in treatment and infection control. Spores are highly resistant structures that can survive extreme conditions, including heat, desiccation, and antibiotics, making them challenging to eradicate. Haemophilus, however, remains susceptible to standard disinfection methods and antibiotics, simplifying infection control protocols in healthcare settings.
From a treatment perspective, the non-sporulating nature of Haemophilus means that infections caused by these bacteria, such as otitis media, sinusitis, or pneumonia, can often be effectively managed with targeted antibiotics. For instance, ampicillin, amoxicillin, or third-generation cephalosporins are commonly prescribed for Haemophilus influenzae infections, particularly in children under 5 years old, who are most vulnerable. The absence of spores eliminates the need for sporostatic agents like vancomycin or clindamycin, streamlining therapy and reducing the risk of antibiotic resistance.
Infection control strategies also benefit from Haemophilus’ inability to form spores. Standard precautions, such as hand hygiene with alcohol-based sanitizers (at least 60% ethanol or isopropanol) and surface disinfection with 70% ethanol or sodium hypochlorite (0.5% solution), are sufficient to inactivate these bacteria. This contrasts with spore-forming pathogens, which require more aggressive measures, such as autoclaving or prolonged exposure to sporicidal agents. For healthcare facilities, this translates to cost savings and operational efficiency, as routine cleaning protocols are adequate to prevent Haemophilus transmission.
However, the non-sporulating nature does not diminish the importance of vigilance. Haemophilus can still survive briefly on surfaces or in respiratory droplets, necessitating prompt identification and isolation of infected patients. For immunocompromised individuals or those with underlying respiratory conditions, even non-sporulating bacteria pose a significant risk. Prophylactic measures, such as the HiB vaccine for Haemophilus influenzae type b, remain critical in high-risk populations, particularly infants aged 2–18 months, who receive a 3-dose primary series (at 2, 4, and 6 months) followed by a booster at 12–15 months.
In summary, the non-sporulating nature of Haemophilus simplifies both treatment and infection control, allowing for effective management with standard antibiotics and disinfection practices. Clinicians and healthcare facilities can leverage this biological characteristic to optimize patient care, reduce transmission, and allocate resources efficiently. However, adherence to guidelines and proactive vaccination strategies remain essential to mitigate the risks associated with these infections.
Unlocking Rogue and Epic Modes in Spore: A Comprehensive Guide
You may want to see also
Frequently asked questions
No, Haemophilus bacteria do not form spores. They are non-spore-forming, Gram-negative coccobacilli.
Haemophilus bacteria lack the genetic and metabolic mechanisms required for sporulation, a process typically seen in other bacterial genera like Bacillus and Clostridium.
Haemophilus bacteria are fastidious and require specific nutrients to survive. They are not well-adapted to harsh conditions and rely on their environment for protection.
No, Haemophilus bacteria do not enter a dormant state like spore-forming bacteria. They remain metabolically active and require a suitable host or environment to survive.
Yes, since Haemophilus bacteria do not form spores, they are primarily transmitted through respiratory droplets or direct contact and cannot survive long outside a host environment.

























